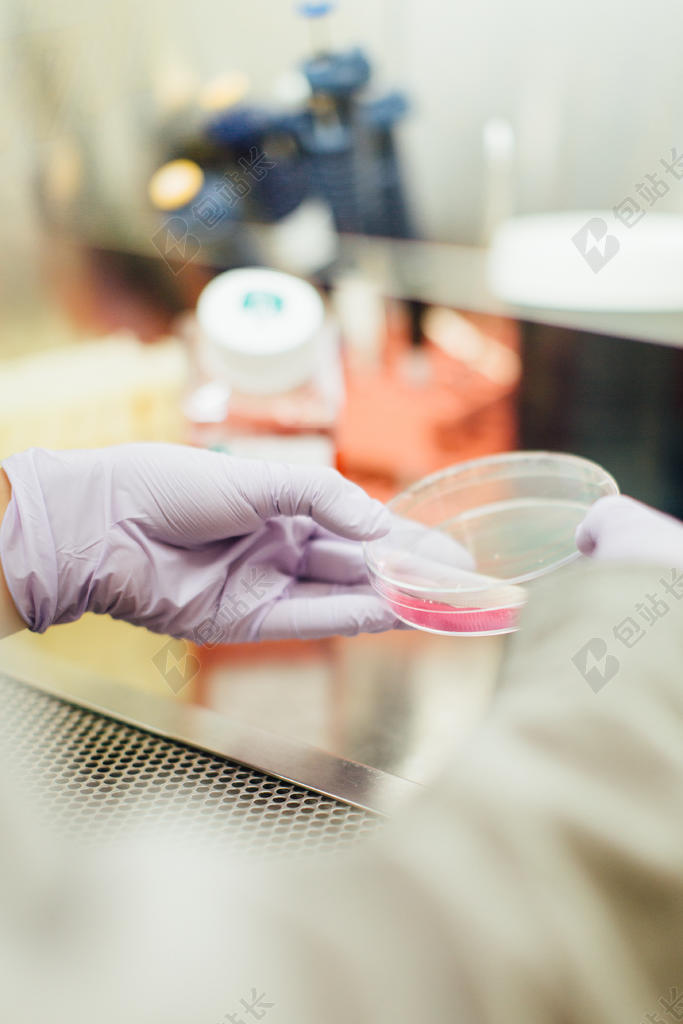
科学细致室内拿着培养皿实验科研背景图片

科学细致室内拿着培养皿实验科研背景图片

包站长提供科学细致室内拿着培养皿实验科研背景图片免费下载,作品有版权,可商用,文字图片等主体内容皆可修改,更多关于背景图片下载,就来包站长。
如需印刷成实物请先认真校稿,避免造成不必要的经济损失。
- 作品编号:20481723
- 文件格式:JPG
- 文件大小:12.3 MB
此作品是用户自行上传分享并拥有版权或使用权,仅供网友学习交流,未经上传用户书面授权,请勿作他用。
包站长提供科学细致室内拿着培养皿实验科研背景图片免费下载,作品有版权,可商用,文字图片等主体内容皆可修改,更多关于背景图片下载,就来包站长。
如需印刷成实物请先认真校稿,避免造成不必要的经济损失。
此作品是用户自行上传分享并拥有版权或使用权,仅供网友学习交流,未经上传用户书面授权,请勿作他用。